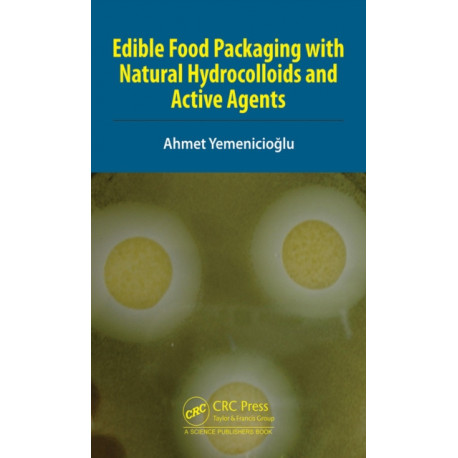
Edible Food Packaging with Natural Hydrocolloids and Active Agents

Kurv
Vare
varer
(tom)
Ingen varer
Fastlægges senere
Forsendelse
0,- kr
I alt
Edible Food Packaging with Natural Hydrocolloids and Active Agents
(Bog, Hardback, Engelsk)
Forlag:
Taylor & Francis Ltd
- Type: Bog
- Format: Hardback
-
Sprog:
Engelsk

- ISBN-13: 9780367350192
- Se flere detaljer ▼
Formater og udgaver
Beskrivelse
The book provides readers with state-of-the-art developments in antimicrobial, antioxidant and bioactive packaging based on natural hydrocolloids and active agents.
Læsernes anmeldelser (0)
Alle detaljer
| Forlag | Taylor & Francis Ltd |
| Forfatter | Ahmet (Izmir Institute of Technology) Yemenicioglu |
| Type | Bog |
| Format | Hardback |
| Sprog | Engelsk |
| Udgivelsesdato | 03-11-2022 |
| Første udgivelsesår | 2022 |
| Illustrationer | 25 Tables, black and white; 13 Line drawings, black and white; 6 Halftones, color; 5 Halftones, black and white; 6 Illustrations, color; 18 Illustrations, black and white |
| Originalsprog | United Kingdom |
| Sideantal | 334 |
| Indbinding | Hardback |
| Forlag | Taylor & Francis Ltd |
| Sideoplysninger | 334 pages, 25 Tables, black and white; 13 Line drawings, black and white; 6 Halftones, color; 5 Half |
| Mål | 161 x 243 x 24 |
| ISBN-13 / EAN-13 | 9780367350192 |

